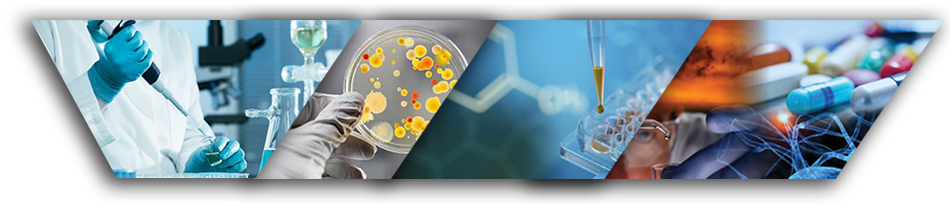

DERGİ HAKKINDA
ISSN:2687-5578
Multidisipliner Klinik Toksikoloji Dergisi/Multidisciplinary Clinical Toxicology Journal Klinik Toksikoloji Derneği'nin resmi bilimsel yayın organıdır. Yayın dili Türkçe ve İngilizcedir.
Dergi üç ayda bir yılda dört sayı (Ocak, Nisan, Temmuz, Ekim) olarak hakemli ve ücretsiz, açık erişim yayınlanan bir dergidir.
Makale değerlendirme ve yayın işlemleri için yazarlardan ücret talep edilmemektedir. Tüm makaleler online makale değerlendirme sistemi kullanılarak dergiye iletilmelidir. Derginin yazım kurallarına, gerekli formlara ve dergiyle ilgili diğer bilgilere web sayfasından ulaşılabilir.